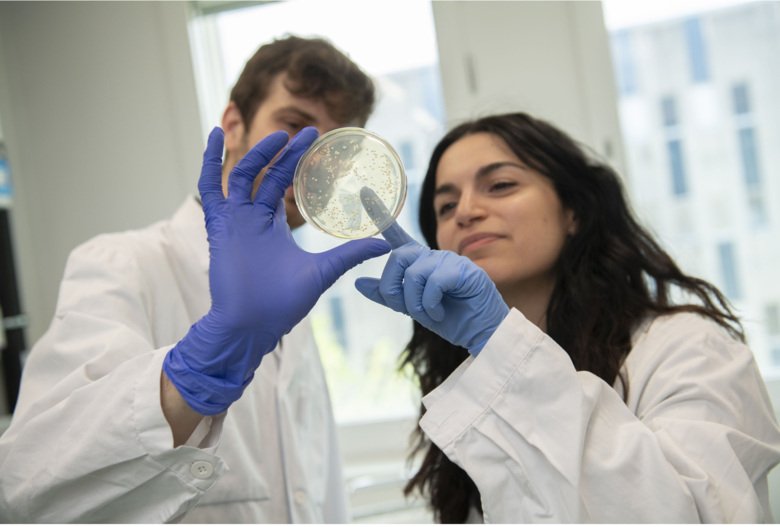
Two scientists with blue gloves are analysing an agar plate

News from NextGenNK 2022
Photo: Ulf Sirborn
- NextGenNK in the Swedish newspaper Dagens Industri
- The Directors of NextGenNK participate in NK2022
- ATMP World Tour 2022
- NextGenNK researchers at InCheck kick-off
- NextGenNK leadership talking about NK cells in podcasts
Awards and recognitions 2022
- Arnika Wagner - Topic-in-Focus Advanced Research Grant, EHA grants program
- Maria Karvouni - IMS Young Investigator Award for Exemplary Abstract, the International Myeloma Society
- Katharina Susek - IMS Young Investigator Award for Exemplary Abstract, the International Myeloma Society
- Arnika Wagner - KID funding
- Katharina Susek - Best Oral Presentation Award, Collaboration in Science 2022
- Nutsa Burduli - Best Oral Presentation Award, Tissue & Motion Conference 2022
- Alvaro Haroun-Izquierdo's article - Editors Picks in JITC
